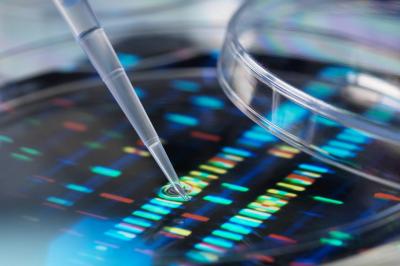

Egy spanyol felmérés szerint tíz háztartásból hatban tartanak valamilyen háziállatot. Általában ez kutya vagy macska, de a hörcsögtől és a madaraktól kezdve a vadászgörényen, a vadnyúlon keresztül a pókokig és a hüllőkig terjedően széles a skála, és ezek mindegyike okozhat allergiát – mondta lapunknak dr. Márk Zsuzsanna, a Budai Egészségközpont allergológusa.
A lakásban tartott kedvencek szőrén, hámján kívül a nyáluk és a vizeletük, illetve mindenféle mirigytermékük részecskéi is a levegőbe kerülnek. Télen, amikor még az ablakokat is zárva tartjuk, nagyobb koncentrációban lélegezzük be ezeket az anyagokat, a padlófűtés pedig tovább ront a helyzeten. Nem véletlen, hogy olyankor a háziporatka mellett a kedvencek okozta allergiás tünetek is felerősödnek – mondta a szakorvos.
Mit lehet tenni?
Egyértelmű jele az allergiának, ha állatsimogatás után kiütések alakulnak ki, vagy otthon állandóak a szénanáthás, de akár asztmás tünetek, durvább esetben életet veszélyeztető anafilaxiás reakció jelentkezik. Szénanáthás panaszokra antihisztamint lehet szedni, és/vagy használható antihisztamin vagy szteroid tartalmú orrspray, de szükség esetén asztma elleni szerek is. A többi allergiánál alkalmazható immunterápiás kezelés is segíthet. Ilyenkor az allergizáló anyagot emelkedő dózisban bejuttatják a szervezetbe, így olyan antitestek termelődnek, amelyek segítségével a szervezet megszokja és tolerálja azt. Ez, a világszerte elfogadott módszer azonban nem minden allergénre jó, és mivel az állatok sem egyformák, nem biztos, hogy minden immunterápiás készítmény alkalmas minden allergia gyógyítására. Leginkább javasolt „gyógymód” az állat eltávolítása: kertbe költöztetése vagy elajándékozása. Erre azonban a legtöbb gazdit nem könnyű rávenni – jegyezte meg a szakorvos, hozzátéve, hogy minden allergiás betegség legegyszerűbb kezelési módszere az allergén távol tartása.
Ha allergiás az állatszőrre,
- ne menjen cirkuszba, állatkertbe!
- ne tartson otthon állati szőrből készült tárgyakat!
- ne aludjon lószőrmatracon!
- ne engedje a kedvencét a hálószobába, különösen az ágyba!
- kutyázás, cicázás után alaposan mosson kezet!
- minimalizálja az allergének megtapadásának esélyét: ne legyenek a lakásban szőnyegek, kárpitozott bútorok!
Steril szoba?
Vannak olyan kutatások, amelyek azt vizsgálják, hogy allergéngazdag vagy -mentes környezet egészségesebb-e. Egyes eredmények szerint a fokozatos alkalmazkodás ellenállóbbá teheti az immunrendszert. Ezek ugyan még nem lezárt vizsgálatok, de valószínű, hogy steril környezetben másképp fejlődik a gyerekek immunrendszere, mint az allergénektől nem mentesben. Több vizsgálat is arra az eredményre jutott, hogy a túlzott tisztaság és az ennek érdekében használt, túl sok vegyi anyag hozzájárulhat az allergiások számának világszerte tapasztalható növekedéséhez.